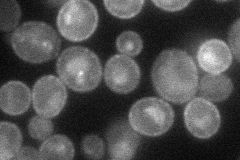
YBL042C
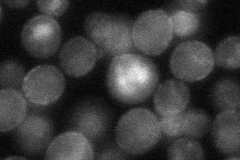
YBL042C
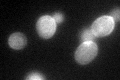
YBL042C
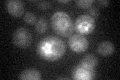
YBL042C

View description
High affinity uridine permease, localizes to the plasma membrane; also mediates low but significant transport of the cytotoxic nucleoside analog 5-fluorouridine; not involved in uracil transport
Localization:
Intensity:
Fold change:
Significance:
-
C’ GFP library in SD

cell periphery55.68 -
N' NOP1pr-GFP in SD
cell periphery,vacuole43.7615 -
N' TEF2pr-mCherry in SD

cell periphery,bud neck51.5953 -
N' NATIVEpr-GFP in SD
cell periphery38.6034 -
N' TEF2pr-VC and Cyto-VN in SD

below threshold28.1393 -
C’ GFP library in SD+DTT
cell periphery46.460.83No -
C’ GFP library in SD+H2O2

punctateN/AN/ANo -
C’ GFP library in Starvation Media

vacuoleN/AN/AYes -
C’ GFP library on the background of Pup2-DaMP
nuclear periphery -
C’ GFP library on the background of CCT mutant

cell periphery46.18790.829371No
